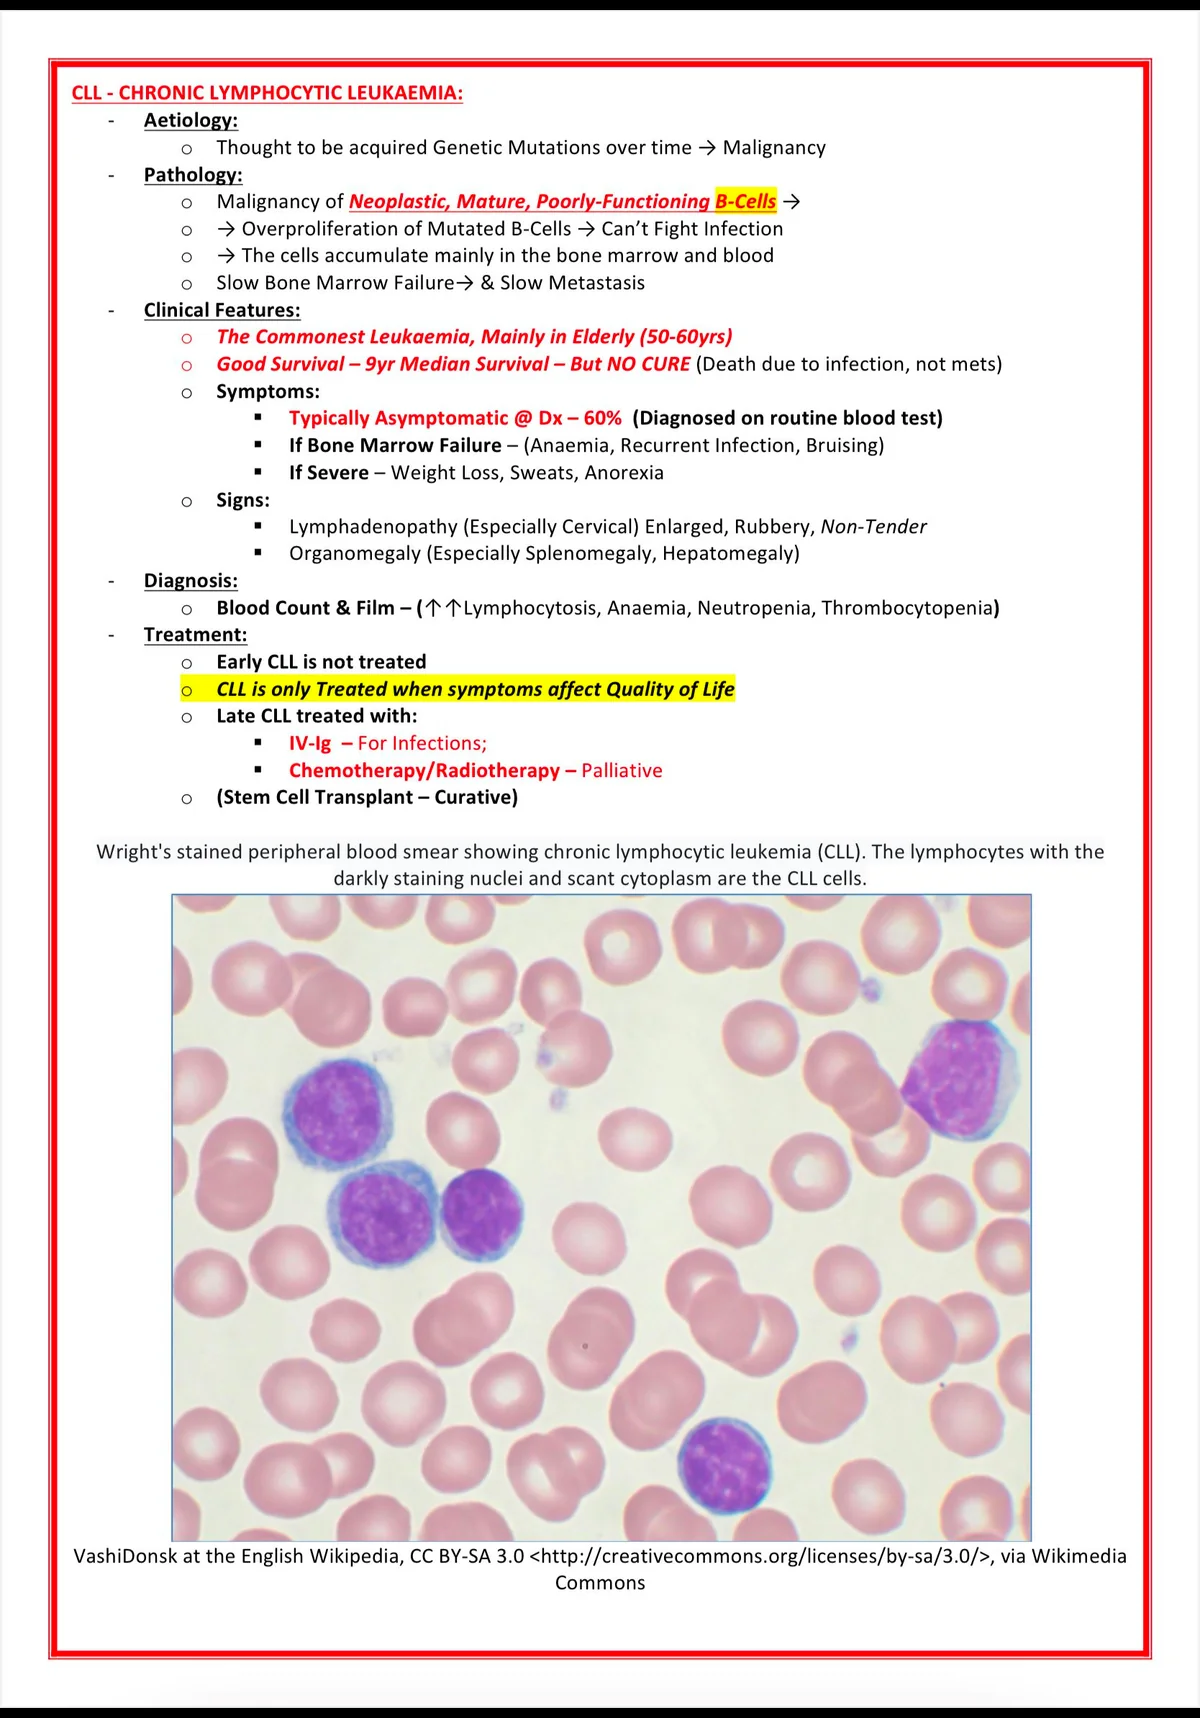

OR GET 80% OFF THIS SUBJECT IN THE BUNDLE DEAL HERE!
HAEMATOLOGY NOTES
(DELIVERED INSTANTLY TO YOUR INBOX IN PDF FORMAT)
What’s included: Ready-To-Study Anatomy, Physiology, Pathophysiology, and Pathology Notes of the Haematological System.
Features:
- Succinct
- Richly illustrated
- Downloadable & Printable PDF documents.
- Compatible with OneNote, Notability & Goodnotes
Content Volume: 109 pages
Anatomy & Physiology Notes:
- BLOOD: AN OVERVIEW
- HAEMATOPOIESIS
- RED BLOOD CELLS
- HAEMOSTASIS/HEMOSTASIS
- THE ROLE OF BLOOD IN THE IMMUNE SYSTEM
- BLOOD GROUPS, TRANSFUSION & BLOOD PRODUCTS
Pathology Notes:
- ANAEMIAS
- IRON DEFICIENCY ANAEMIA (Microcytic)
- ANAEMIA OF CHRONIC Inflammatory DISEASE (Microcytic/Normocytic)
- THALASSAEMIAS
- SICKLE CELL ANAEMIA
- MACROCYTIC ANAEMIA
- “HA” – HAEMOLYTIC ANAEMIA
- HAEMOLYTIC DISEASE OF THE NEWBORN
- APLASTIC ANAEMIA (Ie. MARROW FAILURE)
- POLYCYTHAEMIA
- HAEMOCHROMATOSIS
- MYELODYSPLASTIC (PRELEUKAEMIC) SYNDROMES
- MULTIPLE MYELOMA
- LEUKAEMIAS
- ALL – ACUTE LYMPHOBLASTIC LEUKAEMIA
- AML – ACUTE MYELOID LEUKAEMIA
- CLL – CHRONIC LYMPHOCYTIC LEUKAEMIA
- CML – CHRONIC MYELOID LEUKAEMIA
- LYMPHOMAS
- HODGKIN’S LYMPHOMA (15%)
- NON-HODGKIN’S LYMPHOMAS (85%)
- BLEEDING DISORDERS
- THROMBOTIC DISORDERS
- DRUGS FOR HAEMOSTASIS:
- ANTI-COAGULANTS
- ANTI-PLATELET DRUGS
- THROMBOLYTICS
…OR Get OUR 80% OFF VALUE BUNDLE HERE!

Be the first to review “Haematology Notes”